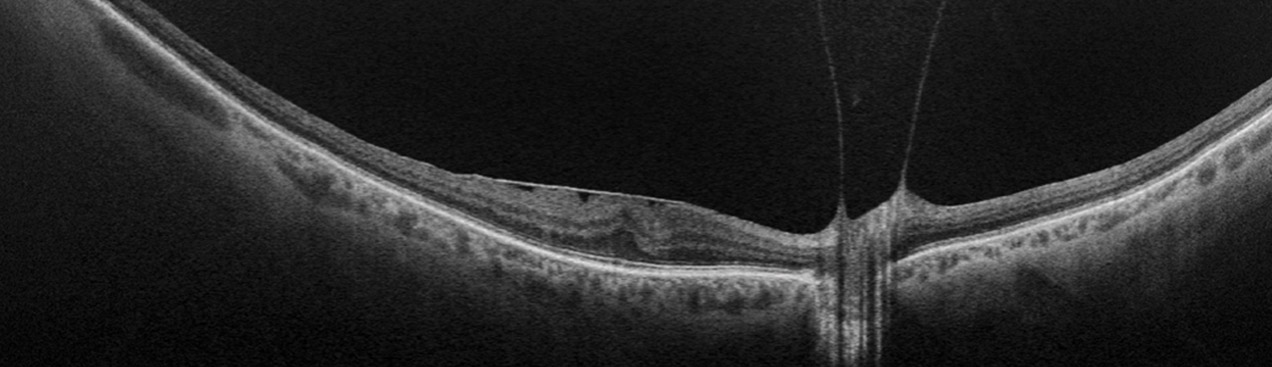
color rgb from Silverstone RGB

optomap Guided OCT
improves patient management
optomap guided OCT enhances patient management by combining ultra-widefield imaging with OCT guidance to deliver a more complete view of retinal health. This approach helps clinicians detect critical findings earlier, reduce the risk of misdiagnosis, and make more informed treatment decisions. By integrating widefield capture with guided OCT scans, practices can streamline workflow, increase diagnostic confidence, and provide patients with a higher level of care and personalized management.
Clinical Summary
Referenced Papers
Feasibility and Clinical Utility of Ultra-Widefield–Navigated Swept-Source Optical Coherence Tomography Imaging.
Kovacs, K.D., et al.
Using Ultrawide Field-Directed Optical Coherence Tomography for Differentiating Nonproliferative and Proliferative Diabetic Retinopathy.
Ashraf, M., et al.
Feasibility of peripheral OCT imaging using a novel integrated SLO ultra-widefield imaging swept-source OCT device.
Sodhi, S.K., et al.
Single-capture ultra-widefield guided swept-source optical coherence tomography in the management of rhegmatogenous retinal detachment and associated peripheral vitreoretinal pathology.
Lee et al.
Morphological Features of Regulated vs. Dysregulated Rhegmatogenous Retinal Detachment Using Swept-Source Optical Coherence Tomography.
Pecaku, A., et al.
Silicone oil emulsification: A literature review and role of widefield imaging and ultra-widefield imaging with navigated central and peripheral optical coherence tomography technology
Valentín-Bravo, F. J., Stanga, P. E., Reinstein, U. I., Stanga, S. E. F., Martínez-Tapia, S. A., & Pastor-Idoate, S.
The role of ultra-widefield imaging with navigated central and peripheral cross-sectional and three-dimensional swept source optical coherence tomography in ophthalmology: Clinical applications
Stanga, Paulo E.; Valentín-Bravo, Francisco J.; Reinstein, Ursula I.; Saladino, Andrea; Arrigo, Alessandro; Stanga, Sebastian E. F.
Comparison of a Novel Ultra-Widefield Three-Color Scanning Laser Ophthalmoscope to Other Retinal Imaging Modalities in Chorioretinal Lesion Imaging.
Nagel, I. D., et al.
optomap Multimodal Guided Cases
Optos offers multimodal imaging with all ultra-widefield devices. Having both ultra-widefield and four images captured in less than one second has been shown to enhance pathology detection and disease management as well as improve practice and clinic flow. Ultra-widefield multimodal imaging is important across all access points of patient care - screening, detection, diagnosis, and treatment.































































































































